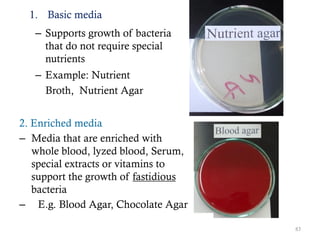
1. Basic media
– Supports growth of bacteria
that do not require special
nutrients
– Example: Nutrient
Broth, Nutrient Agar
2. Enriched media
– Media that are enriched with
whole blood, lyzed blood, Serum,
special extracts or vitamins to
support the growth of fastidious
bacteria
– E.g. Blood Agar, Chocolate Agar
83
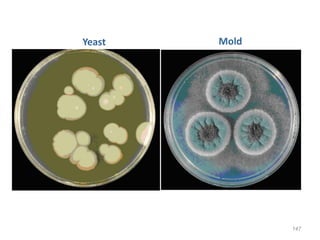
147
Yeast Mold
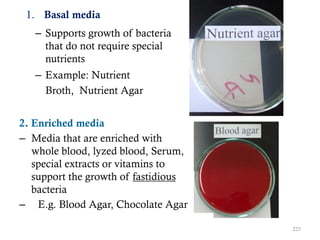
1. Basal media
– Supports growth of bacteria
that do not require special
nutrients
– Example: Nutrient
Broth, Nutrient Agar
2. Enriched media
– Media that are enriched with
whole blood, lyzed blood, Serum,
special extracts or vitamins to
support the growth of fastidious
bacteria
– E.g. Blood Agar, Chocolate Agar
225
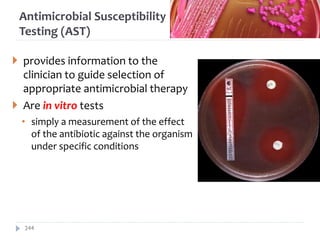
Antimicrobial Susceptibility
Testing (AST)
 provides information to the
clinician to guide selection of
appropriate antimicrobial therapy
 Are in vitro tests
• simply a measurement of the effect
of the antibiotic against the organism
under specific conditions
244

The document is a course outline for a microbiology program at Africa Medical College, focusing on various aspects of microbiology including bacteria, viruses, fungi, and their classifications. It covers topics such as general microbiology, systematic bacteriology, medical microbiology, and the germ theory of disease, along with assessment methods for students. Additionally, it outlines the structures and functions of microorganisms, providing foundational knowledge for medical microbiology students.

![Fungal classification…
c. Dimorphic fungi
• exhibit thermal dimorphism (i.e., exist as yeast
at body temperature [37°C] and mould at room
temperature [25°C])
• Example
o Histoplasma capsulatum
o Blastomyces dermatitidis
o Coccidioides immitis
o Paracoccidioides brasiliensis
14
8](https://image.slidesharecdn.com/generalmicrobiology-amc-2024complete-250123143432-b2d9fe6c/85/General-Microbiology-AMC-2024_Complete-pdf-148-320.jpg)